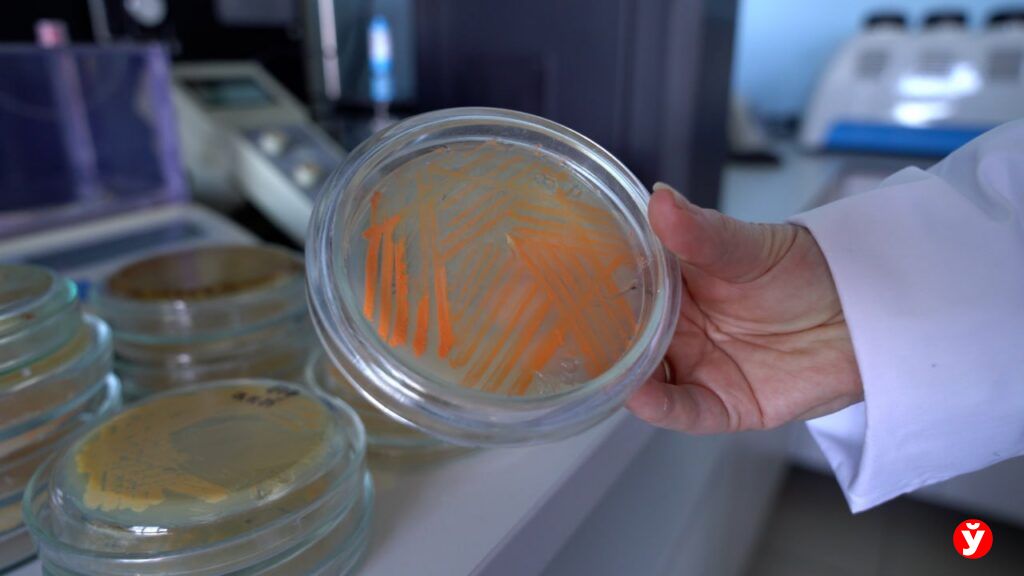

Они едят нефть: белорусские ученые заставили бактерии очищать почву от топлива
Специально выведенные микроорганизмы, поедающие нефть, становятся реальным инструментом спасения загрязнённых земель и вод. Каким образом эти микроорганизмы с легкостью расправляются даже с самыми сложными загрязнениями? «МП» отправилась в лабораторию природоохранных биотехнологий Института микробиологии НАН Беларуси, чтобы узнать, как устроены эти «живые очистители» и почему за ними будущее.
Нефть на завтрак
В основе новой разработки — не просто использование бактерий, разлагающих нефть. Такой подход известен давно: микроорганизмы-деструкторы действительно способны «съедать» нефтепродукты, превращая их в более безопасные вещества. Но у этой технологии есть слабое место — нефть является труднодоступным субстратом для бактерий. Кроме того, она гидрофобна, то есть буквально «отталкивает» воду и всё, что в ней находится.

Именно здесь появляется ключевой элемент нового подхода — биосурфактанты или экологически безопасные поверхностно-активные вещества, вырабатываемые микроорганизмами.
— Биосурфактанты снижают вязкость нефти, превращая ее в эмульсию более доступную для микроорганизмов-деструкторов нефти. За счет этого скорость восстановления нефтезагрязненной почвы возрастает в несколько раз. Вместо трёх месяцев очистка может занять всего один-полтора, – рассказывает заведующий лабораторией природоохранных биотехнологий Института микробиологии НАН Беларуси Елена Глушень.

Но скорость — не единственное преимущество. Куда важнее экологичность. В отличие от синтетических поверхностно-активных веществ, которые широко используются в промышленности, биосурфактанты не токсичны и не подавляют развитие живых организмов. Для сравнения: даже небольшие концентрации обычных ПАВ способны практически остановить жизнедеятельность бактерий в воде. Биологические же аналоги, наоборот, работают в гармонии с природой.

Интересно, что они зачастую оказываются даже эффективнее синтетических веществ. Например, сохраняют активность в условиях высокой солёности, выдерживают широкий диапазон температур и pH — там, где многие синтетические аналоги могут терять эффективность.
— Мы работаем над этим направлением порядка 20 лет. На первом этапе провели поиск микроорганизмов, которые могут быть использованы для решения наших задач. Проверили до 1000 штаммов. В результате остановились на 8 штаммах, которые наиболее активно выделяют нужные соединения. Основной упор сделали на бактерии, относящиеся к родам Bacillus и Rhodococcus, или так называемые бациллы и родококки. Именно они показали наилучшие результаты: устойчивость, стабильность и способность работать в самых разных условиях, — добавляет заведующий лабораторией Елена Глушень.


От сточных вод до косметологии
Эти микроорганизмы можно назвать настоящими «трудягами». Их потенциал далеко не ограничивается ликвидацией нефтяных разливов. Биосурфактанты уже находят применение в очистке сточных вод — особенно на предприятиях, связанных с мясопереработкой, производством жиров и масел. Они помогают расщеплять гидрофобные загрязнения и снижают нагрузку на очистные сооружения. Кроме того, ведутся исследования их применения в сельском хозяйстве, медицине и косметологии — благодаря антибактериальным и даже противовирусным свойствам.
И, пожалуй, главный вывод, который делают учёные: микроорганизмы — это не просто объект исследований, а полноценный инструмент решения экологических проблем. Они работают эффективно, безопасно и там, где традиционные технологии оказываются бессильны или малоэффективны. Возможно, именно за такими «невидимыми помощниками» и стоит будущее экологической очистки — быстрее, чище и без вреда для природы.


Это актуально для Беларуси?
— Самое главное применение биосуфактантов — это в первую очередь экология и защита окружающей среды. Например, где-то разлилась нефть, масла, либо поступило много жиров в очистные сооружения. Эта технология может быть использована на заправках, нефтедобывающих, нефтетранспортных предприятиях, — пояснила Елена Глушень. — На основе этих микроорганизмов, способных вырабатывать биосурфактанты, мы разработали ряд препаратов. Некоторые из них уже давно и успешно используются. Эти препараты предназначены для очистки сточных вод, осложненных высоким содержанием жиров и нефтепродуктов. В настоящий момент совместно с ОАО «Гомельтранснефть Дружба» проходят опытно-промышленные испытания технологии ускоренной ремедиации нефтезагрязненных почв биопрепаратами комплексного действия с использованием биосурфактантов. И мы надеемся, что в следующем году мы запустим цикл производства новых препаратов на основе микроорганизмов-продуцентов ПАВ.
Рекомендуем